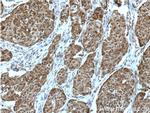
PIAS3 Antibody in Immunohistochemistry (Paraffin) (IHC (P))

Search
Proteintech
PIAS3 Polyclonal Antibody
{{$productOrderCtrl.translations['antibody.pdp.commerceCard.promotion.promotions']}}
{{$productOrderCtrl.translations['antibody.pdp.commerceCard.promotion.viewpromo']}}
{{$productOrderCtrl.translations['antibody.pdp.commerceCard.promotion.promocode']}}: {{promo.promoCode}} {{promo.promoTitle}} {{promo.promoDescription}}. {{$productOrderCtrl.translations['antibody.pdp.commerceCard.promotion.learnmore']}}
产品信息
13486-1-AP
种属反应
宿主/亚型
分类
类型
抗原
偶联物
形式
浓度
规格
纯化类型
保存液
内含物
保存条件
运输条件
产品详细信息
The PIAS3 antibody detects PIAS3 (68 kDa) as well as its sumoylated form (85 kDa) in some normal mouse tissues, breast and brain tumor cell lines.
Immunogen sequence: VRQLTAGTL LQKLRAKGIR NPDHSRALIK EKLTADPDSE VATTSLRVSL MCPLGKMRLT VPCRALTCAH LQSFDAALYL QMNEKKPTWT CPVCDKKAPY ESLIIDGLFM EILSSCSDCD EIQFMEDGSW CPMKPKKEAS EVCPPPGYGL DGLQYSPVQG GDPSENKKKV EVIDLTIESS SDEEDLPPTK KHCSVTSAAI PALPGSKGVL TSGHQPSSVL RSPAMGTLGG DFLSSLPLHE YPPAFPLGAD IQGLDLFSFL QTESQHYGPS VITSLDEQDA LGHFFQYRGT PSHFLGPLAP TLGSSHCSAT PAPPPGRVSS IVAPGGALRE GHGGPLPSGP SLTGCRSDII SLD (277-628 aa encoded by BC030556)
靶标信息
The PIAS (protein inhibitor of activated STAT) proteins play a crucial role as transcriptional coregulators in various cellular pathways, including the STAT, p53 and the steroid hormone signaling pathway. The PIAS protein family includes at least five evolutionarily conserved genes, including PIAS3. The major function of the PIAS proteins is the control of gene transcription and can also act as small ubiquitin-like-modifier (SUMO) E3 ligases. PIAS3 binds specifically to STAT3 following the stimulation of STAT3. Increased expression of PIAS3 has been observed in several human cancers, including lung, breast, and brain tumors, but not in anaplastic lymphoma kinase-positive T/null-cell lymphomas, indicating that PIAS3 plays multiple roles in different tissue and cell types.
仅用于科研。不用于诊断过程。未经明确授权不得转售。
生物信息学
蛋白别名: E3 SUMO-protein ligase PIAS3; E3 SUMO-protein transferase PIAS3; KChAP; PIAS3; potassium channel regulatory protein KChAP; Potassium channel-associated protein; Protein inhibitor of activated STAT protein 3; unnamed protein product; zinc finger, MIZ-type containing 5
基因别名: PIAS3; Pias3l; ZMIZ5
UniProt ID: (Human) Q9Y6X2, (Mouse) O54714, (Rat) O70260
Entrez Gene ID: (Human) 10401, (Mouse) 229615, (Rat) 83614